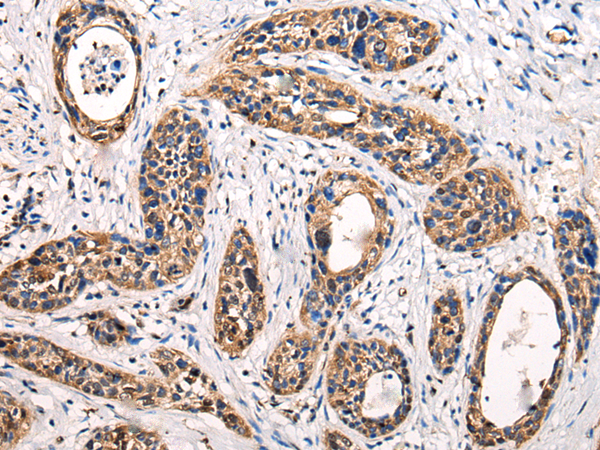

中文名稱:兔抗ATG9B多克隆抗體
|
Background: |
This gene functions in the regulation of autophagy, a lysosomal degradation pathway. This gene also functions as an antisense transcript in the posttranscriptional regulation of the endothelial nitric oxide synthase 3 gene, which has 3' overlap with this gene on the opposite strand. Mutations in this gene and disruption of the autophagy process have been associated with multiple cancers. Alternative splicing results in multiple transcript variants. |
|
Applications: |
ELISA, IHC |
|
Name of antibody: |
ATG9B |
|
Immunogen: |
Fusion protein of human ATG9B |
|
Full name: |
autophagy related 9B |
|
Synonyms: |
SONE; APG9L2; NOS3AS |
|
SwissProt: |
Q674R7 |
|
ELISA Recommended dilution: |
5000-10000 |
|
IHC positive control: |
Human cervical cancer |
|
IHC Recommend dilution: |
25-100 |
購物車
幫助
021-54845833/15800441009
